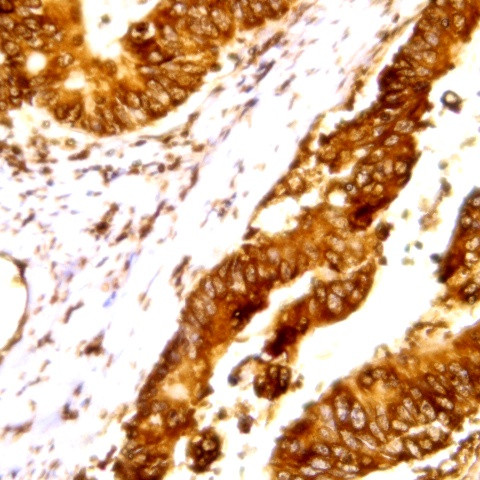
Cdk3 Antibody in Immunohistochemistry (Paraffin) (IHC (P))

Search
AbboMax
Cdk3 Polyclonal Antibody
{{$productOrderCtrl.translations['antibody.pdp.commerceCard.promotion.promotions']}}
{{$productOrderCtrl.translations['antibody.pdp.commerceCard.promotion.viewpromo']}}
{{$productOrderCtrl.translations['antibody.pdp.commerceCard.promotion.promocode']}}: {{promo.promoCode}} {{promo.promoTitle}} {{promo.promoDescription}}. {{$productOrderCtrl.translations['antibody.pdp.commerceCard.promotion.learnmore']}}
图: 1 / 1
Cdk3 Antibody (500-7264) in IHC (P)

产品信息
500-7264
种属反应
宿主/亚型
分类
类型
抗原
偶联物
形式
浓度
纯化类型
保存液
内含物
保存条件
运输条件
产品详细信息
Positive control: Human lymphoma
Cellular location: Nuclear, Cytoplasmic.
靶标信息
CDK3/CyclinE1is a member of the cyclin-dependent protein kinase family and promotes entry into S phase, in part by activating members of the E2F family of transcription factors. CDK3 can also associate with cyclin C and phosphorylates the retinoblastoma 1 protein to promote exit from G0. The CDK3 gene has been mapped to chromosomal location of 17q22-qter, telomeric to the BRCA1 gene by somatic cell hybrids analysis. The presence of a single point mutation in the CDK3 gene from several Mus musculus strains commonly used in the laboratory has been reported.
仅用于科研。不用于诊断过程。未经明确授权不得转售。
篇参考文献 (0)
生物信息学
蛋白别名: Cell division protein kinase 3; Cyclin-dependent kinase 3
基因别名: 2310050O10Rik; CDK3; CDKN3
UniProt ID: (Human) Q00526
Entrez Gene ID: (Human) 1018, (Mouse) 69681